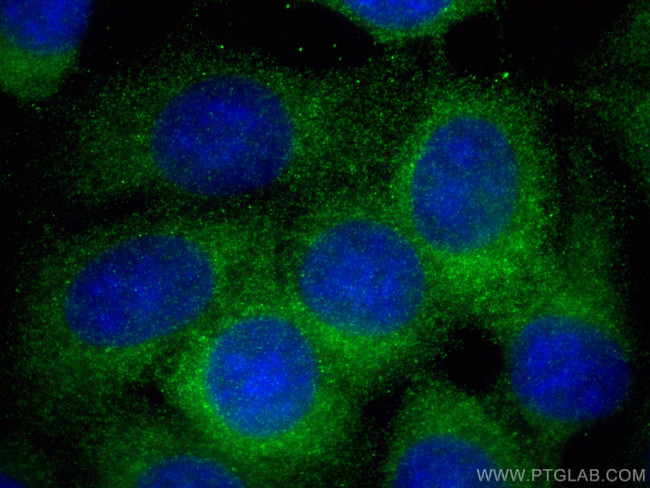
PI4KA Antibody in Immunocytochemistry (ICC/IF)

Search
Proteintech
PI4KA Recombinant Rabbit Monoclonal Antibody (230057G2)
{{$productOrderCtrl.translations['antibody.pdp.commerceCard.promotion.promotions']}}
{{$productOrderCtrl.translations['antibody.pdp.commerceCard.promotion.viewpromo']}}
{{$productOrderCtrl.translations['antibody.pdp.commerceCard.promotion.promocode']}}: {{promo.promoCode}} {{promo.promoTitle}} {{promo.promoDescription}}. {{$productOrderCtrl.translations['antibody.pdp.commerceCard.promotion.learnmore']}}
产品信息
82938-1-RR
种属反应
宿主/亚型
Expression System
分类
类型
克隆号
抗原
偶联物
形式
浓度
纯化类型
保存液
内含物
保存条件
运输条件
产品详细信息
Immunogen sequence: YLAKFKVKRC GVSELEKEGL RCRSDSEDEC STQEADGQKI SWQAAIFKVG DDCRQDMLAL QIIDLFKNIF QLVGLDLFVF PYRVVATAPG CGVIECIPDC TSRDQLGRQT DFGMYDYFTR QYGDESTLAF QQARYNFIRS MAAYSLLLFL LQIKDRHNGN IMLDKKGHII HIDFGFMFES SPGGNLGWEP DIKLTDEMVM IMGGKMEATP FKWFMEMCVR GYLAVRPYMD AVVSLVTLML DTGLPCFRGQ TIKLLKHRFS PNMTEREAAN FIMKVIQSCF LSNRSRTYDM IQYYQNDIPY
靶标信息
PI4KB and PI4KA are the two human type III PI4 kinases, which share sequence similarly with PI3 kinases and phosphorylate the 4 position of phosphotidyl inositol. The mammalian PI 4-kinases have been classified into two types, II and III, based on their molecular mass, and modulation by detergent and adenosine. The protein encoded by PI4KA is a type III enzyme that is not inhibited by adenosine. Two transcript variants encoding different isoforms have been described for PI4KA.
仅用于科研。不用于诊断过程。未经明确授权不得转售。
篇参考文献 (0)
生物信息学
蛋白别名: leuserpin 2; phosphatidylinositol 4-kinase; phosphatidylinositol 4-kinase 230; phosphatidylinositol 4-kinase a; Phosphatidylinositol 4-kinase alpha; Phosphatidylinositol 4-Kinase III alpha; phosphatidylinositol 4-kinase, catalytic, alpha; phosphatidylinositol 4-kinase, catalytic, alpha polypeptide; phosphatidylinositol 4-kinase, type III, alpha; PI4-kinase alpha; PI4K-alpha; ptdIns-4-kinase alpha; testicular secretory protein Li 35
基因别名: PI4K-ALPHA; pi4K230; PI4KA; PIK4; PIK4CA; PMGYCHA
UniProt ID: (Human) P42356, (Mouse) E9Q3L2
Entrez Gene ID: (Human) 5297, (Rat) 64161, (Mouse) 224020